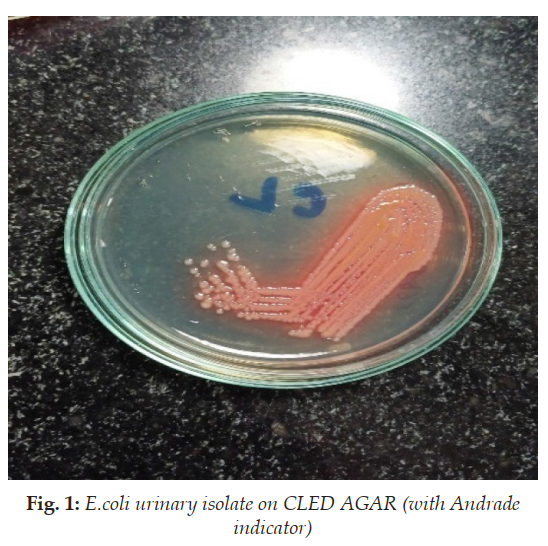
Image 1

Review Article
Extraintestinal infections by Escherichia coli
Sayan Bhattacharyya , Mohana Chakraborty1 , Sayan Bhattacharyya
Licence:
RFP Indian Journal of Hospital Infection 6(1):p 17-20, Jan-June 2024. | DOI: n.a
How Cite This Article:
Mohana Chakraborty, Sayan Bhattacharyya. Extraintestinal infections by Escherichia coli. RFP Ind. Jr. Hosp. Inf., 2024,6(1):17–20.
Timeline
Abstract
Extra intestinal Pathogenic Escherichia coli (ExPEC) is a leading cause of invasive infections. These include entities like bacteremia, respiratory tract infections, meningitis and sepsis among others. Invasive ExPEC infection complicates the clinical treatment of other conditions. It is also associated with increased mortality, duration of hospital stay, and worse clinical outcomes. Older adults having comorbidities are at highest risk of acquiring these infections. ExPEC is of particular interest in the AsiaPacific region, due to aging populations and increasing antimicrobial resistance.
References
No records found.
About this article
Cite this article
Mohana Chakraborty, Sayan Bhattacharyya. Extraintestinal infections by Escherichia coli. RFP Ind. Jr. Hosp. Inf., 2024,6(1):17–20.
Licence:
| Received | Accepted | Published |
|---|---|---|
| N/A | N/A | N/A |
DOI: n.a
Keywords
ExPEC; Bacteremia; UTISearch for Similar Articles
Similar Articles
- Surgical Site Infections: A Review and the Critical Role of Nurses in Preventio...
- Microbial Degradation of Bioplastics: Mechanisms, Challenges, and Future Prospe...
- Incidence and Grading of Surgical Site Infections Using the Southampton System...
- TP53 as a Tumor Suppressor Gene
- Prevailing Hospital Acquired Infections a Challenge to Safety of Patients and Ho...
Article Level Metrics
Last UpdatedMonday 26 January 2026, 23:32:12 (IST)
Accesses
Citations
Download citation
Article Keywords
Keyword Highlighting
Highlight selected keywords in the article text.
Timeline
| Received | N/A |
| Accepted | N/A |
| Published | N/A |